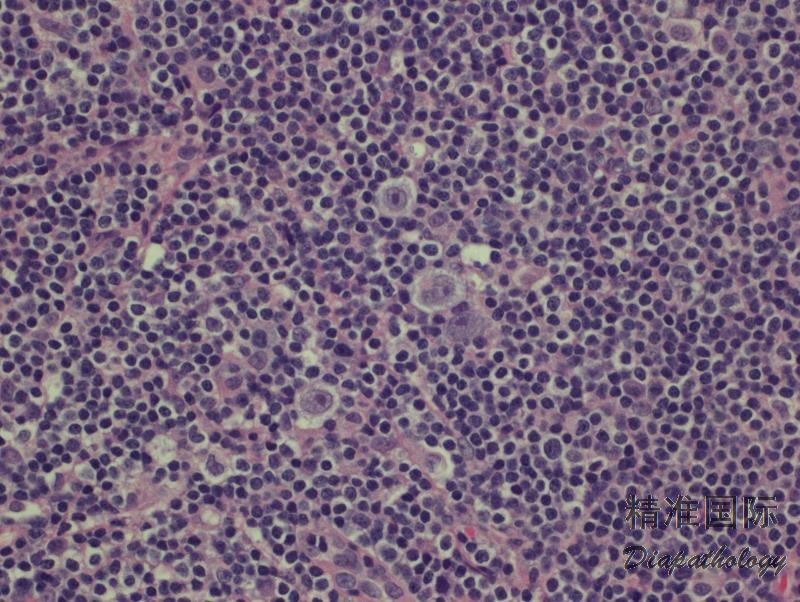

淋巴细胞丰富型经典型霍奇金淋巴瘤
Lymphocyte-Rich Classical Hodgkin Lymphoma, LRCHL
概述:
霍奇金淋巴瘤(Hodgkin lymphoma, HL)是一种来源于单克隆 B 细胞的肿瘤,分为结节性淋巴细胞为主型霍奇金淋巴瘤(nodular lymphocyte predominant Hodgkin lymphoma, NLPHL)和经典型霍奇金淋巴瘤(classical Hodgkin lymphoma, CHL)。后者又分为四种组织学亚型:结节硬化型经典霍奇金淋巴瘤(NSCHL)、淋巴细胞丰富型经典霍奇金淋巴瘤(LRCHL)、混合细胞型经典霍奇金淋巴瘤(MCCHL)、淋巴细胞消减型经典霍奇金淋巴瘤(LDCHL)。 CHL 的组织学共同特征是少量的 Hodgkin 细胞(单核)或 Reed-Sternberg 细胞(多核)散在分布于大量的反应性背景细胞中,它们包括淋巴细胞、嗜酸细胞、粒细胞、浆细胞和组织细胞及不等量胶原纤维。 LRCHL 亚型组织学表现为少量 HRS 细胞散在分布于呈结节状或偶尔弥漫生长的小淋巴细胞背景中,无粒细胞和嗜酸细胞,无纤维化。
诊断要点:
少见的亚型,发病年龄较其它亚型大,男性多见。常见为外周淋巴结,纵隔很少受累。
有两种生长模式:结节型和弥漫型。绝大多数病例呈结节型生长,结节为扩大的套区,有时可见偏心的生发中心。典型的 HRS 细胞散在分布结节中,有时肿瘤细胞类 LP 细胞。粒细胞和嗜酸细胞罕见(结节之间)或缺如。无纤维化。少数病例背景淋巴细胞呈现弥漫生长模式,常混有组织细胞。
免疫组化:肿瘤细胞 CD30+,CD15+/-,PAX5+,MUM-1+,CD20-/+,OCT2-/+,BOB1-/+,EBER+(40%),CD79a- ,CD45-,EMA-,ALK-。背景细胞表达全 B 抗原,但弥漫型可有大量 T 细胞。部分病例可见 T 细胞环绕 HRS 细胞。

免疫组织化学染色:
肿瘤细胞 CD30+,CD15+/-,PAX5+,MUM-1+,CD20-/+,OCT2-/+,BOB1-/+,EBER+(40%),CD79a-,CD45-,EMA-,ALK-。背景细胞表达全 B 抗原,但弥漫型有大量 T 细胞。
鉴别诊断:
- 结节性淋巴细胞为主型霍奇金淋巴瘤 (NLPHL): 结节由反应性小 B 细胞组成,不含生发中心(偶见淋巴结边缘残存滤泡),散在典型 LP 细胞,其周围环绕以 T 细胞(CD3+/CD4+/PD1+),CD57+ T 细胞有时也会增加并环绕 LP 细胞。LP 细胞表达 CD20. CD79a、PAX5,但 CD30 阴性或偶尔弱阳性,一般不表达 CD15。EBER 阴性。
- T 细胞/组织细胞丰富型大 B 细胞淋巴瘤** (THRLBCL):与弥漫型 LRCHL 有相似之处。呈现弥漫模式,背景细胞为小淋巴细胞和组织细胞,散在不典型大细胞(<10%)。大细胞形态可类似中心母细胞、免疫母细胞、LP 细胞或霍奇金细胞。但肿瘤细胞表达全 B 细胞抗原,如 CD20. CD79a 和 PAX5,通常不表达 CD30,少数病例或有较弱或部分细胞表达;不表达 CD15; EBER 一般也阴性。
- B 小淋巴细胞淋巴瘤 (SLL)伴 HRS 细胞 :背景细胞形态学和免疫学表现为典型的 CLL/SLL 特征:CD20+(弱)、CD5+、cyclin D1-,HRS 样细胞 CD30+,CD15+/-,EBER+。无炎性背景细胞。
预后:
预后较其它亚型稍好,与 NLPHL 相似,但后者复发较多见。
